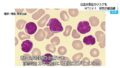

- 1 : 2025/11/25 20:22:06 ???
-
2025.11.25
週刊現代
『仮面の告白』『金閣寺』で知られる、戦後日本文学界の白眉・三島由紀夫。日本を愛し、憲法改正を声高に主張した勇猛果敢な作家の最期は、陸上自衛隊駐屯地での割腹自殺という凄惨なものだった。
2025年は三島由紀夫自決から55年である上に、三島由紀夫生誕100周年の節目の年である。「三島由紀夫が今の日本を見たらなんと言うか」という月並みな妄想に溺れるのではなく、改めて彼の自決が何を意味したのかを再考する必要があるのではないか。1970年11月25日、三島由紀夫は一体何をしたのか?
週刊現代1970年12月10日号の「私だけが見た惨劇の一部始終」より再編集してお届けする。
『「顔面蒼白で刀を振りかざし、次々に切り付け」…三島事件から55年、立てこもり事件の“人質”が語る「惨劇の一部始終」』より続く。
第5回
「やめんか!命は大切にしろ!」…三島事件から55年、割腹自決を3メートル先で見た“元軍人”が語った「介錯の刃のひらめき」『仮面の告白』『金閣寺』で知られる、戦後日本文学界の白眉・三島由紀夫。日本を愛し、憲法改正を声高に主張した勇猛果敢な作家の最期は、陸上自衛隊駐屯地での割腹自殺という凄惨なものだった。2025年は三島由紀夫自決から55年である上に、三島由紀夫...gendai.media目前の自刃は「言葉に表現できぬショック」
- 3 : 2025/11/25 20:23:38 K2L9Q
- 緒形拳の映画で見たシーンだな
- 4 : 2025/11/25 20:26:56 5siOj
- 介錯務めたやつが下手くそで何回もやってようやく切断したらしいな
- 5 : 2025/11/25 20:27:49 mYvGm
- >>4
首を切るのは技量が要求されるからね
江戸時代は専門の人がいたし - 9 : 2025/11/25 20:44:39 YnQ3W
- >>4
失敗続けたやつから代わったやつが一撃で決めたんじゃなかったっけ - 13 : 2025/11/25 20:50:55 5siOj
- >>9
そうなんだ。何度も斬りつけられて痛かっただろうな - 15 : 2025/11/25 21:02:26 uU7l8
- >>9
恐怖で手元狂いそう - 6 : 2025/11/25 20:31:29 DZUQH
- 陸上自衛隊員に明治時代の陸軍に対して決起を呼びかけるが如き叫びとか
現実盲目の基地外みたい
- 26 : 2025/11/25 23:19:55 uaHHb
- >>6
その伝わらなさ、現役隊員たちの無関心さも含めて、ある主の破滅と狂気の美があんだよ。 - 7 : 2025/11/25 20:41:04 wNkyG
- ガトツゼロスタイル!
- 30 : 2025/11/25 23:42:46 PSZcg
- >>7
カゼッタ岡? - 8 : 2025/11/25 20:43:04 fzUoK
- >>1
むかし三島の首画像ネットに流れてたな - 11 : 2025/11/25 20:47:39 L0mnD
- とは言え今の世はほぼ三島が危惧した通りになった
- 12 : 2025/11/25 20:49:22 BepL2
- >>11
何がどうなったって? - 14 : 2025/11/25 20:53:16 L0mnD
- >>12
「無機的な、からっぽな、ニュートラルな、中間色の、富裕な、抜け目がない、或る経済大国」になった - 21 : 2025/11/25 22:29:41 ZYMhl
- >>14
ねちっこく有機的だし、中道を保持できるほど腰が据わってもいないし、世界レベルでみて富裕ってほどでもない、抜け目なく立ち回ってたら上記を実現できたかもしれんがねぇ
たまたまいい目が出たときに調子づいてただけだよ - 16 : 2025/11/25 21:20:41 yqZqJ
- 潮騒とか読んだらこの人ナルシストだなと思った。
- 17 : 2025/11/25 21:21:50 Vt7ky
- それで、BSPで「黒蜥蜴」をやってたのか
- 18 : 2025/11/25 21:36:21 9YYfs
- 三島由紀夫と言えば筋トレと男色
- 19 : 2025/11/25 21:50:54 zFMbY
- 何故切腹ぬんかしたんだ?
意味わからん - 20 : 2025/11/25 22:04:19 YbC6O
- サムライだったのだろう…
サムライの精神とか全く知らんけど…((((゜д゜;)))) - 22 : 2025/11/25 22:44:52 cUk7U
- 江戸時代中期辺りになると実際には腹は切らなかったってお
切腹用の短刀に触れるのを合図に介錯人が首をはねるだけ - 23 : 2025/11/25 22:45:46 535fC
- ぬふぅ…誤チェストでごわす!
- 24 : 2025/11/25 23:00:36 zbWEp
- もし生きてたら100歳だねありえなくもない
もし生きてたら今の日本をどう思うのだろうか - 25 : 2025/11/25 23:17:40 ZfppG
- 楯の会、三島由紀夫が自費で隊員の制服を三越にてオーダーメイドで作ってたんだってね。
街の中をあんな格好で行進してたり、ちょっと引く。 - 27 : 2025/11/25 23:26:04 ZfppG
- 70年安保闘争に乗じて自衛隊を治安維持で出動させ
クーデター起こして憲法改正を狙ってたが
要の自衛隊が動かなくての割腹自殺だったような? - 28 : 2025/11/25 23:38:09 uaHHb
- >>27
市ヶ谷のバルコニーから自衛隊員達に檄を飛ばしたんだけど、けっこう無視されたり、ヤジられたり、誰ひとり真面目に聞いてなかったのよ。 - 29 : 2025/11/25 23:40:14 7aZ0R
- 昔、消毒液をいれた洗面器が置いてあったな。今はどうなんやろ?
【特集】 「やめんか!命は大切にしろ!」…三島事件から55年、割腹自決を3メートル先で見た”元軍人”が語った「介錯の刃のひらめき」
talkニュー速+
コメント